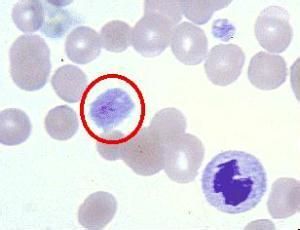
血癌

概述
 血癌
血癌症狀
 血癌
血癌2)發熱 急性白血病的首發症狀多為發熱,可表現為弛張熱、稽留熱、間歇熱或不規則熱,體溫在37.5~40℃或更高。時有冷感,但不寒戰。
3)出血 是白血病的常見症狀。出血部位可遍及全身,尤以鼻腔、口腔、牙齦、皮下、眼底常見,也可有顱內、內耳及內臟出血。
4)貧血 早期即可發生貧血,表現為面色白、頭暈、心悸等。
5)肝脾腫大 有50%的白血病病人會出現肝脾腫大,以急性淋巴細胞性白血病的肝脾腫大最為顯著。
6)淋巴結 全身廣泛的淋巴結腫大,以急性淋巴細胞性白血病為多見,但急淋不如慢淋顯著。淺表淋巴結在頸、頜下、腋下、腹股溝等處,深部淋巴結在縱隔及內臟附近。腫大的淋巴結一般質地軟或中等硬度,表面光滑無壓痛、無粘連。
7)皮膚及黏膜病變 伴隨白血病的皮膚損害表現為結節、腫塊、斑丘疹等。黏膜損傷表現為鼻黏膜、呼吸道黏膜和口腔黏膜等處發生腫脹和潰瘍等。
8)神經系統炎症蛛網膜、腦膜等處可以發生白細胞浸潤,表現頗似腦瘤、腦膜炎等,患者會出現顱內壓增高、腦膜刺激、肢體癱瘓等症狀。
9)骨骼及關節病變 病變浸潤骨骼及關節後,常發生骨骼及關節疼痛,表現為胸骨、肱骨以及肩、肘、髖、膝關節等處出現隱痛、酸痛,偶有劇痛。兒童急性淋巴細胞性白血病多出現骨及關節壓痛。
10)其他 白血病細胞可浸潤呼吸、消化和泌尿生殖系統,以及眼眶、淚腺及眼底等,患者可出現肺部彌散性或結節性改變,同時伴有胸腔積液、消化功能紊亂、蛋白尿、血尿、閉經或月經量過多、眼球突出、視力減退等症狀。
分類
血癌
血癌急性骨髓性白血病(AML):急性骨髓性白血病好發於成年人,約有80%的病人超過25歲。急性骨髓性白血病可再細分類為M1到M7型;M1型是「急性未成熟骨髓芽球性白血病」;M2是「急性成熟骨髓芽球性白血病」;M3是「急性多顆粒前骨髓細胞性白血病」;M4是「急性骨髓單核球性白血病」;M5是「急性單核球性白血病」;M6是「急性紅血球性白血病」;M7是「急性巨核細胞性白血病」。
慢性骨髓性白血病(CML):慢性骨髓性白血病好發年齡層20歲~45歲的成年人。與費城染色體的異常有關,可再分為幼年型及成年型。
急性淋巴球性白血病(ALL):急性淋巴球性白血病好發於兒童,急性淋巴球性白血病又可再分為L1、L2、L3型。
慢性淋巴球性白血病(CLL):好發50歲以上的老年人。淋巴球可分為B細胞及T細胞,故可再分為慢性B淋巴球性白血病以及慢性T淋巴球性白血病。
病因
白血病的成因複雜,目前可能的致病原因及看法包括: 放射線:正常人罹患血癌的機率約在兩萬五千分之一左右,但在核子彈爆炸圈的倖存居民,罹患白血病的機率竟然高達六十分之一。另外懷孕婦女的腹部X光照射,出生的小孩罹患白血病的機率也較高。
化學藥劑:長期的接觸有機苯的工人,或曾接受過含氫化合物(Alkylating agents)化學治療的病人。
遺傳及基因突變:先天染色體異常,如唐氏症候群(Down's)、布倫氏症候群(Bloom's)等先天疾病可能會誘導白血病的發生。如家族中罹患急性白血病,則罹病的機率也會比較高。
免疫能力:自體免疫能力的缺陷可能與慢性淋巴球性白血病有關。
病毒感染:第一型人類T淋巴球細胞性病毒HTLV-I病毒感染與成年型T細胞白血病有關。
科研探討
遺傳基因
 血癌
血癌基因治療用正常DNA取代癌細胞的異常DNA,從而恢復對細胞生長的正常控制。
通過對白血病的DNA轉變的研究,醫生已能使用高精度的測試方法用於檢查這種疾病。例如,聚合酶連鎖反應就能通過白血球的基因錯位或重整來鑑別它們。這種檢查方法可以從一百萬個正常細胞中發現一個腫瘤細胞。它可用於考察治療方法消滅白血病的徹底程度,從而決定需不需要進一步的治療
臨床試驗
幾個重要的問題正在進行臨床試驗,其中包括:
· 為什麼30%的患急性淋巴細胞性白血病(ALL)的兒童會舊病復發,以及怎樣預防?
· 有無靈敏度更高的預兆因子可用來鑑別需要進一步強化治療的兒童?
· 能否增強化療來更為有效地治療急性髓細胞性白血病細胞,以及用生長因子來幫助恢復小孩正常的骨髓活動?
· 抵抗急性髓細胞性白血病的化療藥物會反轉嗎?
· 有沒有用於治療白血病更好的藥物?
· 藥物、毒素或放射能否通過抗體的作用,只專門針對白血病細胞?抗體用來挑選出白血病,然後用藥物、毒素或放射加以破壞。
· 能否自然產生“生物反應修正劑”來幫助身體的免疫系統抵抗白血病細胞?
· 第9條和第22條染色體發生錯位的小孩的治癒前景如何?帶有這種特定錯位白血病細胞的兒童痊癒率很低。
一種專門用於殺死這種錯位細胞的藥物正在進行臨床試驗。
治療的有效方法
自體骨髓移植
 血癌
血癌1986年,解放軍307醫院成功開展了自體骨髓移植。那是一位22歲的公司女職員,因突發高燒、鼻孔出血,被診斷為急性淋巴細胞白血病。307醫院骨髓移植小組的醫務人員對其實施了自體骨髓移植。這種移植的方法是,醫生先抽出患者體內的骨髓進行處理,爾後對患者進行全身大劑量放、化療,殺死體內的癌細胞,再將取出的骨髓回輸到患者體內,並不斷繁殖增生。此時,患者入住“一塵不染”的無菌艙,實行全環境保護和特殊護理。移植後49天,患者的骨髓、血象逐漸恢復,一個月後達到正常人水平。
異體骨髓移植
骨髓移植真正用於治療白血病,是源於建國後發生的國內第一起嚴重放射事故。
1963年11月底,安徽農學院的鈷60放射源“失蹤”了。一位名叫葛傳福的當地青年農民在池塘邊發現了一個被密封的鉛罐。出於好奇,他對鉛罐一番搗鼓,看到了裡面有個發亮的金屬塊,誤以為是“寶物”,當即揣進衣袋跑回家中。下午,他開始噁心、嘔吐不止。當晚和衣與哥哥、弟弟睡在一起。夜裡,叔叔來葛家辦事並住下。到翌晨起床,他共受9個多小時的照射。
 血癌
血癌村民把病人送到了解放軍307醫院。雖然醫院主攻放射病,但畢竟還沒有真正收治過一例放射病人。擔任救治組長、我國最早從事放射病研究的葉根耀教授,對4位放射病人實施骨髓移植和綜合治療手段獲得成功,病人至今和正常人一樣健康生活,創造了放射病治療的奇蹟。
這組放射病的成功搶救,使葉教授和醫務人員把眼光轉移到白血病的治療上,似乎看到了多年的夢想有望成為現實。此後,葉根耀教授開始探索利用治療放射病的經驗,擴展到治療白血病上,就是對白血病患者進行大劑量照射,人為地使患者造成急性放射病,把白血病人轉換成急性放射病人,然後再按照已有的治療急性放射病的輸注健康骨髓等成功方法治療急性放射病。1980年,他們用這種方法治療再生障礙性貧血等血液病病人。
這個時候,國際上的骨髓移植髮展較快。葉教授因成功救治4例放射病病人而在國際同行中引起高度關注,多次應邀參加國際學術會議和合作研究,了解並掌握了國外骨髓移植方面的先進技術。不久,307醫院組建了我國第一個HLA實驗室和兩間潔淨病房,前者是為了配合骨髓移植的配型研究,也就是驗證供受者之間的人類白細胞抗原是否完全吻合;後者是供病人移植入住,實行保護性隔離,以防感染。
時隔一年,他們對一名患有急性白血病的大學生實施了異基因骨髓移植。與自體不同的是,異基因骨髓移植是將別人的骨髓輸注到患者體內,將受者病態骨髓通過大劑量放化療全部摧毀,將HLA配型組合的健康供者骨髓輸注給受者,並使之在受者體內獲得再生,重建受者的造血及免疫功能。幸運的是,患者與哥哥的骨髓相吻合。一個月後,哥哥的骨髓在弟弟體內成活,造血功能得以恢復。
幹細胞移植
 神奇的人體備份器——幹細胞
神奇的人體備份器——幹細胞1995年6月,一位北京患者到307醫院求治,經專家診斷為慢性白血病,需行骨髓移植手術。但與患者配型吻合的供髓者卻不願讓醫生抽髓。
陳主任斷然決定,抽其外周血進行幹細胞移植。供者同意這種方式。但當時此法在國內尚無先例,國際上尚處起步階段。
1995年11月,醫生們從供者體內抽取外周血兩次共分離出100毫升幹細胞,然後輸入到患者體內。經過1個多月的精心醫治和護理,患者康復出院。
這是一個不同尋常的手術,是我國治療白血病的一次重大突破。它用異體外周血幹細胞移植替代了過去抽取骨髓的歷史,只需從供者體內分離出約100毫升含有造血幹細胞的血液進行移植就可以了,相對抽取骨髓的做法,此法供者無痛苦,病人白細胞生長快,並能抑制以往骨髓移植後患者各種感染的併發症。
這一新技術被評為1996年中國醫藥十大科技新聞,成為目前國內外普遍採用的首選方法。至今,307醫院骨髓移植中心已完成異基因外周血幹細胞移植100餘例,成功率居國內前列,在這一領域始終保持國內領先地位。
HLA半相合移植
 血癌
血癌然而要命的是,異體移植要求選擇與患者白細胞抗原完全相合的供髓者,即便是同胞兄弟姐妹也只有1/4的希望,在非親屬中尋找的機率是1/30萬,真正是大海撈針。由於受配型和經濟條件的雙重限制,能夠進行移植獲得生機的患者不過1%。更令人擔憂的是,我國已進入獨生子女時代,家庭日趨小型化,白血病又多發於青少年,只能在非親屬中尋找供髓者,而我國骨髓庫目前登記人數不過幾千人,且缺乏資金,尚未正式有效運行,這條路顯然難以走下去。
在尋找與患者配型完全相合骨髓這條路子越來越窄甚至走不通的情況下,另闢蹊徑治療白血病也就成為國內外學者普遍關注而又亟待解決的課題。
1994年,國外學者提出並開始實施HLA半相合移植。307醫院骨髓移植科緊緊瞄準國際醫學前沿,抓住HLA半相合移植作為攻關對象,並取得了成功。
俊鵬,一位12歲的廣東小男孩,1994年3月發病,診斷為急性淋巴細胞白血病。1998年12月,小俊鵬在父親的陪同下來到307醫院骨髓移植科,醫務人員決定為他移植其父親的骨髓。
1999年1月22日,醫生從其父親身上分兩次採集外周血,經特殊處理後輸入小俊鵬體內。移植後第13天,他血液中的白細胞數增長到每立方毫米1000以上,血小板數增長到每立方毫米2萬多。但20天后開始下降。醫務人員決定再次為他輸注骨髓和外周血造血幹細胞。14天后,他的造血功能重建。一個月後白細胞和血小板數恢復到正常人標準。移植後100天,供受者DNA指紋圖譜證實骨髓植入成功。如今,小俊鵬重新背起書包,和同齡孩子一樣,坐在了明亮的教室里聽老師講課。
HLA半相合移植成功使更多白血病患者有了治癒的希望,患者只要父母健在就有可能接受這一治療。患者同胞兄弟姐妹HLA與其半相合的幾率可達50%,遠比完全相合的幾率高得多,這對於白血病患者來說,無疑是一個福音。
磁化細胞分離
由於諸多原因,能夠進行移植治療的還是少數。陳虎主任說,只有依靠科技創新,不斷拓展治療白血病的新手段,才能為更多的白血病患者帶來希望。
1999年2月,我國首例接受磁化細胞分離新技術移植的患者,在307醫院移植中心康復出院。
按以前的方法,對多發性骨髓瘤病人只能施行自體外周血幹細胞移植。這種方法的不足是,儘管在術前對病人進行化療處理,但移植物裡面仍存留少量腫瘤細胞,無法將其剔除乾淨,如此再回輸到病人體內就有潛在的復發可能。這次,醫務人員對患者回輸的細胞經過純化分離提取,沒有腫瘤細胞和雜物。這在過去是不可想像也是無法做到的。
要做到這點,需要臨床級磁化細胞分選系統。它是將病人的外周血按照優劣進行篩選,剔除其中的腫瘤細胞和雜物,再將由此得到的高純化的幹細胞回輸到病人體內,這樣就會最大限度減少病情復發,提高病人生存質量。
針對自體移植後復發率較高的問題,5年前,他們首次在國際上採用體外擴增自體樹突狀回輸法,有效地解決了自體移植後白血病復發這一難題,至今已移植40多例。而後又在國內開展了無關供者移植、CD34陽性細胞移植、成人臍血移植等,成為全軍第一個細胞與基因治療中心。如今,他們對造血幹細胞可實行程式移植,即不同時期輸入不同功能的乾阻細胞。這些細胞事先在體外經過有效處理,從而減少副作用。現用這種方法已擴展到其他腫瘤病種的治療上。如今,治療白血病不再是過去單一的骨髓移植,而是根據病人的自身情況,採取多種方法醫治。從自體骨髓移植、異基因骨髓移植、外周血幹細胞移植到HLA半相合移植、磁化細胞分離技術等,白血病不斷被征服,白血病患者也不斷從中看到生命的曙光。
口服砒霜療法
香港大學醫學院成功把口服砒霜,研發成處方藥物,是首隻完全由香港研發的處方藥物。超過100名血癌病人服用及接受治療後,已經康復。
港大醫學院表示,適當份量砒霜的潛在毒性,可被解除,服用後對心臟的副作用,可以大大減低。除血癌外,也可用於治療淋巴癌等其他癌症。
港大已為口服砒霜,取得“美國國家專利”,校方正研究為開發中國家病人提供免費口服砒霜。
此外,雖然標靶藥效果良好,但費用開支高達每月約2萬港元,暫時只有醫院管理局轄下撒瑪利亞基金提供資助申請。護理
 血癌
血癌二、在化療期間和化療後應減少或避免探視,不到公共場所活動。
三、地面要清潔消毒,室內紫外線照射消毒,保持室內空氣新鮮。
四、每日用淡鹽水或呋喃西林含漱液漱口,以防止口腔感染,保持大小便通暢,注意肛門周圍的清潔,大便後可用高錳酸鉀溶液坐浴。
五、飲食搭配要合理,攝入蛋白質及維生素含量高的食物,多食新鮮蔬菜水果、禁食辛辣油膩食物並忌菸酒。
六、生活起居要規律,慎避寒暑,勞逸結合,調情志,忌郁怒,保持心情舒暢,使機體處於良好的狀態。“正氣存內,邪不可乾。”
七、禁止服用對骨髓細胞有損害的藥物如:氯黴素、乙雙嗎啉等。
八、避免接觸有毒化學物質如苯及苯的衍生物及避免接觸電離輻射。
九、適當加強體育鍛鍊,從而提升抗病能力。如學練郭林氣功、真氣運行法及太極拳等。
十、定期複查血常規、骨穿及肝腎功的檢查,以了解病情現況,有利於病情的進一步治療。
發病機率
根據國外統計,白血病約占腫瘤總發病率的3%左右,是兒童和青年中最常見的一種惡性腫瘤。白血病的發病率在世界各國中,歐洲和北美發病率最高,其死亡率為3.2-7.4/10萬人口。亞洲和南美洲發病率較低,死亡率為2.8-4.5/10萬人口。

